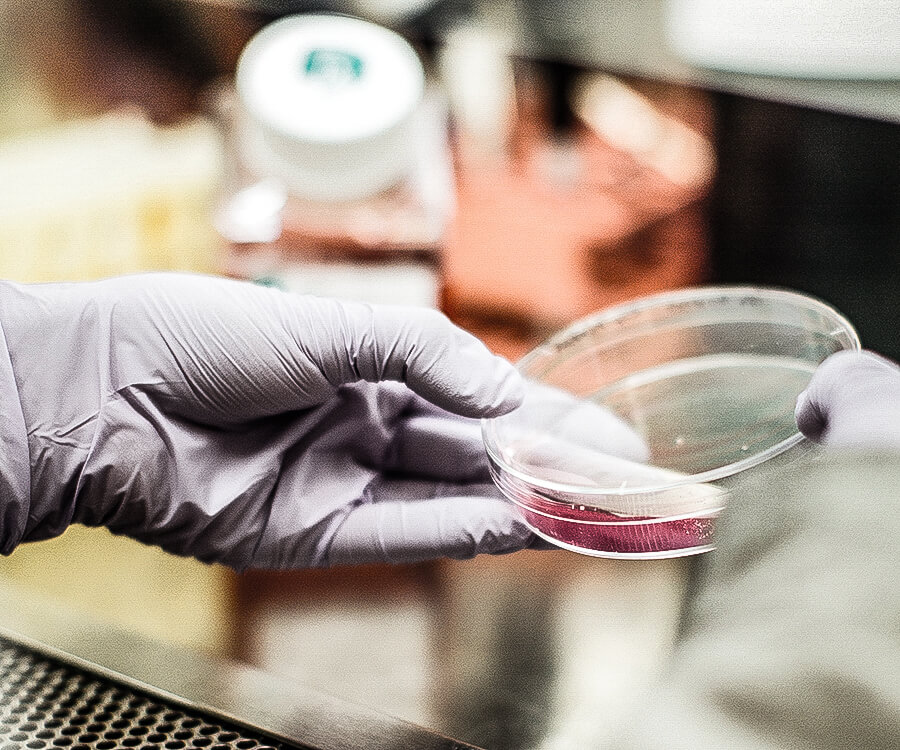

Description
- Available in powdered and non-powdered
- Available in nitrile, latex and vinyl
- Chemical and abrasion resistant
- Flexible
- Great for: materials handling, product inspections, laboratories, oil and gas industry, food handling, pharmaceutical industry, medical grade, etc.
- Available in sizes S-XL
- Meets ASTM and FDA standards

Reviews
There are no reviews yet.